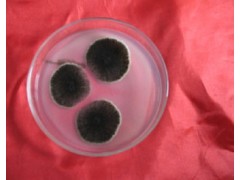

性状:黑色粉末。
有效活孢子含量≥20亿∕克。
Aspergillus niger ,半知菌亚门,丝孢纲,丝孢目,丛梗孢科,曲霉属真菌中的一个常见种。广泛分布于世界各地的粮食、植物性产品和土壤中。是重要的发酵工业菌种,可生产淀粉酶、酸性蛋白酶、纤维素酶、果胶酶、葡萄糖氧化酶、柠檬酸、葡糖酸和没食子酸等。
菌丛黑褐色,顶囊大球形,小梗双层,分生孢子为球形,呈黑、黑褐色,平滑或粗糙。对紫外线以及臭氧的耐性强。菌丝发达多分枝,有隔多核的多细胞真菌。分生孢子梗由特化了的厚壁而膨大的菌丝细胞(足细胞)上垂直生出;分生孢子头状如“菊花”。
是制酱、酿酒、制醋的主要菌种。是生产酶制剂(蛋白酶、淀粉酶、果胶酶)的菌种。生产有机酸(如柠檬酸、葡萄糖酸等)。农业上用作生产糖化饲料,饲料发酵剂添加,生物有机肥添加,有机肥发酵剂添加,秸秆腐熟剂添加。